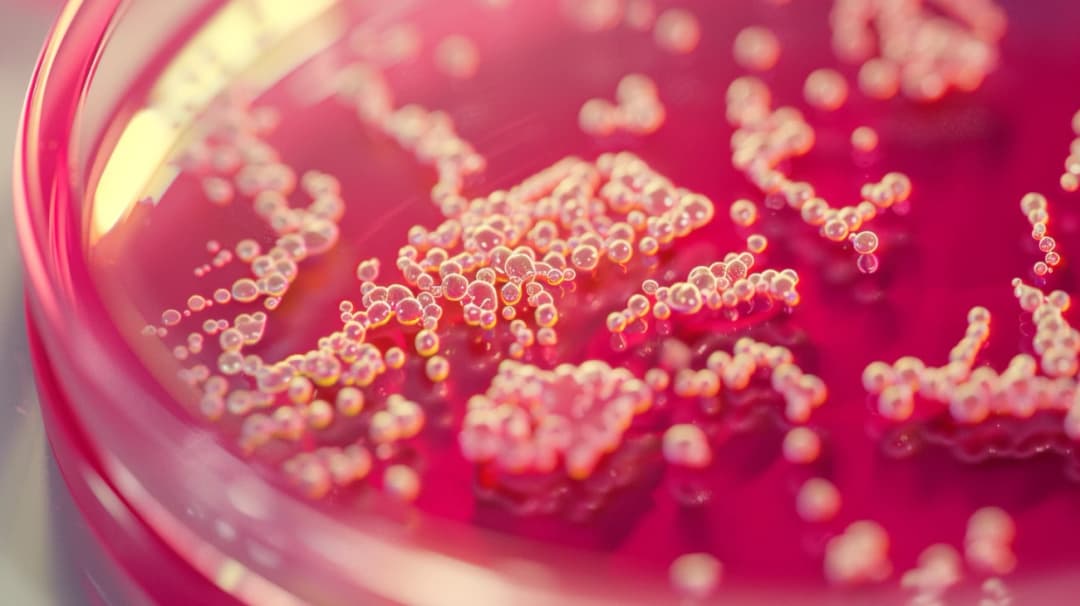
Objawy Helicobacter pylori w kale: Jak je rozpoznać i diagnozować?

Zmaga się z ciągłymi dolegliwościami? Odkryj przyczyny choroby i poznaj skuteczne sposoby, aby sobie z nią radzić. Dowiedz się, jak zmiany stylu życia i właściwa diagnostyka medyczna mogą pomóc w poprawie zdrowia.
Jestem założycielem i głównym autorem portalu o zdrowiu, który powstał z mojej pasji do medycyny i zdrowego stylu życia. Jako wykwalifikowany dietetyk z wieloletnim doświadczeniem, postanowiłem dzielić się wiedzą, która pomaga ludziom żyć pełniej i zdrowiej. Moja misja to dostarczanie rzetelnych, opartych na badaniach informacji o żywieniu, fitnessie i zdrowiu psychicznym. Wierzę, że każdy ma prawo do dostępu do wiedzy, która może znacząco poprawić jakość życia. Dążę do tego, by mój portal był miejscem, gdzie czytelnicy znajdą praktyczne porady, inspiracje oraz wsparcie w dążeniu do lepszego zdrowia.
Zmaga się z ciągłymi dolegliwościami? Odkryj przyczyny choroby i poznaj skuteczne sposoby, aby sobie z nią radzić. Dowiedz się, jak zmiany stylu życia i właściwa diagnostyka medyczna mogą pomóc w poprawie zdrowia.
Krew utajona w kale to często niewidoczny objaw poważnych chorób, takich jak rak jelita grubego. Dowiedz się, co to jest krew utajona, dlaczego jest ważna i jak ją zdiagnozować.
Poznaj innowacyjny probiotyk Biotic Pro, który kompleksowo wspiera zdrowie i dobre samopoczucie. Odkryj korzyści płynące z regularnego stosowania tej wysokiej jakości formuły pro biotic.
Poznaj kompleksową listę produktów low FODMAP - Twój klucz do lepszego samopoczucia. Dowiedz się, które potrawy wybierać, a których unikać, tworząc zrównoważoną dietę FODMAP.
Candida jak leczyć skutecznie wykorzystując naturalne metody? Poznaj sprawdzone sposoby na eliminację grzybicy - od olejków eterycznych i ziół, przez dietę, po wzmacnianie odporności. Skuteczne rozwiązania bez leków.
Dowiedz się, jak działa nieinwazyjny test oddechowy na Helicobacter pylori oraz kiedy warto go wykonać. Poznaj jego korzyści i alternatywne metody diagnozowania tej szkodliwej bakterii.
kaszel, katar, ból gardła czy gorączka. Dowiedz się, jak rozpoznać sygnały infekcji i pomóc dziecku.
Poznaj koszty badania kału na Clostridium difficile. Dowiedz się o możliwościach refundacji i gdzie możesz wykonać to ważne badanie diagnostyczne. Wszystko, co musisz wiedzieć o Clostridium badanie cena.
Co to jest choroba immunologiczna? Poznaj mechanizmy działania układu odpornościowego, objawy, diagnostykę i skuteczne metody leczenia. Dowiedz się, jak rozpoznać pierwsze symptomy i zapobiegać rozwojowi choroby.
Odkryj różnice między Colostrum a laktoferynę - dwiema potężnymi substancjami wspomagającymi układ odpornościowy. Poznaj właściwości, zastosowania i skutki uboczne, aby wybrać optymalny suplement dla siebie.